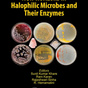
productImage
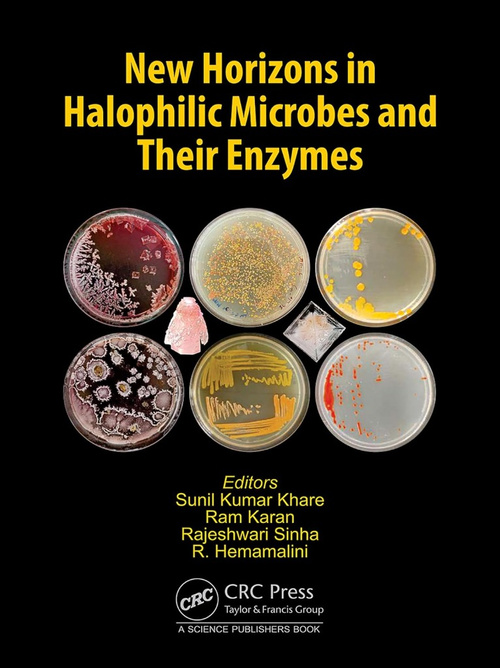

New Horizons in Halophilic Microbes and Their Enzymes 1st Edition
جهت نمایش قیمت و خرید، سایز محصول خود را انتخاب کنید
محصولات مشابه
معرفی محصول
کتاب New Horizons in Halophilic Microbes and Their Enzymes 1st Edition یک منبع بینظیر برای پژوهشگران، دانشجویان و علاقهمندان به زیستشناسی میکروبی و زیستفناوری است. این اثر ارزشمند با تمرکز بر میکروبهای هالوفیل (شورزی) و آنزیمهای شگفتانگیز آنها، دریچهای نو به دنیای زیستشناسی مولکولی و کاربردهای صنعتی باز میکند. در این کتاب، جدیدترین یافتهها در زمینه ساختار، عملکرد و سازگاری میکروبهای شورزی با محیطهای سخت و شور به زبان علمی و قابل فهم ارائه شده است.
نویسندگان برجسته با ارائه مثالهای عملی، نقش کلیدی این میکروارگانیسمها در صنایع غذایی، دارویی، زیستانرژی و محیطزیست را به خوبی تشریح کردهاند. همچنین، بخش ویژهای به آنزیمهای مقاوم به نمک اختصاص یافته و کاربردهای بالقوه آنها در فرآیندهای بیوتکنولوژیک بررسی شده است. اگر به دنبال گسترش افقهای علمی خود و یافتن راهحلهای نوآورانه در حوزه میکروبیولوژی هستید، **خرید کتاب New Horizons in Halophilic Microbes and Their Enzymes 1st Edition** را از دست ندهید.در نتیجه این کتاب، پلی استوار میان علم روز و کاربردهای عملی است و مطالعه آن برای پژوهشگران و فعالان زیستفناوری ضروری خواهد بود.

دیدگاهها